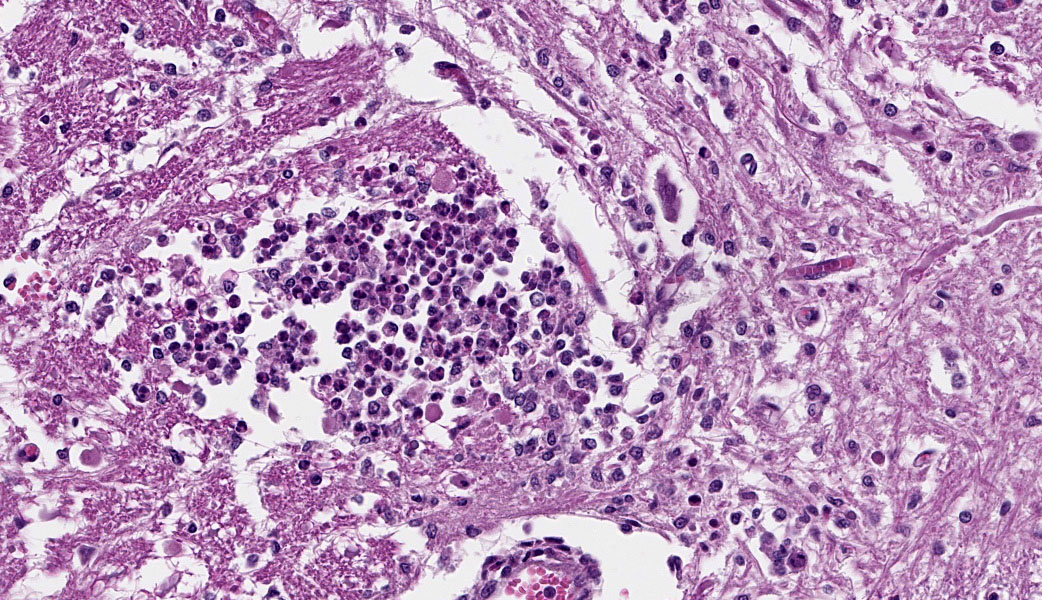

Conerence 18, Case 1
Signalment:
Adult, female, breed unspecified sheep (Ovis aries)
History:
This sheep displayed progressive clinical signs of neurological disease over a three day period culminating in tetraparesis and lateral recumbency, despite treatment with antibiotics, vitamin B complex and corticosteroids.
Gross Pathology:
At necropsy, the cerebrospinal fluid was cloudy and contained strands of fibrin. No other abnormalities were noted.
Laboratory Results:
A replicate section was examined by immunohisto-chemistry using a rabbit polyclonal anti Listeria monocytogenes antibody (#DF2302-50-0, Fisher Scientific, Houston, TX, USA), at a dilution of 1:2000, using the Dako Envision system (Dako Agilent Pathology Solutions, Carpinteria, CA, USA), via an indirect immunoperoxidase procedure. Within the microabscesses in the brain and cervical spinal cord, there were a low to moderate number of bacteria that bound to the primary antibody.
Microscopic Description:
Brain, cerebellum and brainstem: In the brainstem gray matter, there are random multifocal, mild to moderate, variably discrete, infiltrates of hypersegmented and fragmented neutrophils, admixed with fewer mononuclear cells, consistent with microabscesses. Brainstem neurons within and adjacent to the neutrophilic infiltrates are pale, with central chromatolysis, consistent with neuronal degeneration. There are scattered microglial cells, mild gray matter spongiosis and infrequent microhemorrhages. Scattered blood vessels are lined by plump endothelial cells and have perivascular mild infiltrates of predominantly lymphocytes, with fewer neutrophils (perivascular cuffs). The cerebellar leptomeninges are multifocally, mildly infiltrated by predominantly lymphocytes, with fewer admixed neutrophils.
Cervical spinal cord: In the gray matter and white matter, there are scattered, variably discrete, random multifocal, mild to moderate, infiltrates of neutrophils and mononuclear cells, consistent with microabscesses. There is neuronal degeneration, spongiosis, microgliosis, and swollen axons. Blood vessels are lined by plump endothelial cells and have perivascular mild to moderate infiltrates of predominantly lymphocytes, with fewer admixed neutrophils and infrequent plasma cells. The leptomeninges are multifocally expanded by mild to moderate infiltrates of lymphocytes with infrequent admixed neutrophils.
Contributor’s Morphologic Diagnoses:
1. Brain, cerebellum and brainstem: Meningoencephalitis, lymphocytic, multifocal, mild to moderate, with multiple brainstem neutrophilic microabscesses.
2. Cervical spinal cord: Meningomyelitis, lymphocytic, multifocal, moderate, with multiple neutrophilic microabscesses.
Contributor’s Comment:
A replicate section was examined by tissue Gram stain. There were low numbers of gram-positive bacilli, some intracellular, within areas of inflammation. A replicate section was examined by immunohistochemistry, using a rabbit polyclonal anti Listeria monocytogenes antibody (#DF2302-50-0, Fisher Scientific, Houston, TX, USA), at a dilution of 1 :2000, using the Dako Envision system (Dako Agilent Pathology Solutions, Carpinteria, CA, USA), via an indirect immunoperoxidase procedure. Within the microabscesses in the brain and cervical spinal cord, there were a low to moderate number of bacteria that bound to the primary antibody. The microscopic findings in the central nervous system accounted for the clinical signs in this sheep. The microscopic findings were typical of listeric encephalitis in ruminant species and the diagnosis was confirmed by immunohistochemistry.
Listeria monocytogenes is a gram-positive, facultative, anaerobic bacillus common in the environment. The bacteria can multiply within wide temperature and pH ranges. They can tolerate conditions of acidity, salinity and low moisture. They can survive in soil for many months and can be isolated from the feces of healthy cattle. Listeria monocytogenes is an intracellular pathogen of macrophages, neutrophils and epithelial cells. The bacterial surface proteins, Type A and Type B internalins, are virulence determinants. These proteins internalize with E-cadherin, an adherens junction transmembrane glycoprotein, to enable bacteria to cross intestinal, placental and blood brain barriers.
In sheep and other ruminants, listeriosis can manifest as three different syndromes, with little or no overlap. They are likely to be separate clinical presentations. The three syndromes are infection of the pregnant uterus resulting in abortion, blood borne infection with septicemia and with disseminated abscesses, and an ascending encephalitis.
Although listeric encephalitis has been associated with feeding of spoiled silage, environ mental and fecal contamination are more common sources of infection than silage feeding in sheep and goats because many small rumi nants are never fed silage. The onset of the encephalitic form is usually very rapid. Death can ensue 24 to 48 hours after clinical signs appear. Clinical signs of listeric encephalitis in sheep and goats include lethargy, inappetence, loss of coordination, head pressing, circling, blindness, salivation, facial paralysis and culminate in recumbency, convulsions and death. This syndrome is more common in one to three-year-old small ruminants than in older animals.
There are few or no gross lesions in listeric encephalitis. Leptomeningeal opacity and cloudy cerebrospinal fluid may be the only findings seen at necropsy. Typically, microscopic lesions of listeric encephalitis are limited to the brainstem and cervical spinal cord. They include microabscesses, glial nodules, perivascular accumulation of lymphocytes and lymphocytic leptomeningitis. Gram-positive bacilli can be found within the microabscesses.
In listeric encephalitis, the likely route of infection of ingested Listeria bacilli is via breaks in the oral mucous membrane, with subsequent invasion of nerve endings of the trigeminal nerve branches. The bacteria travel via axonal flow to the central nervous system to infect neural cells, generally at the level of the brainstem and cervical spinal cord, where these nerve branches terminate. There may be a trigeminal ganglioneuritis. The bacteria multiply in neuronal cell bodies and then move to the inner side of the neuronal cell membrane via actin-filament mediated mobility. Aggregates of bacteria use a bacterial surface protein (surface protein actA) to move by actin polymerization. A pseudopod containing the bacteria invaginates randomly into an adjacent neural cell, forming a double-membrane bound endocytotic vesicle. This vesicle is lysed by listeriolysin 0, aided by a phospholipase and lecithinase, to release the bacteria into the cytoplasm of the newly invaded neural cell, as direct cell-to-cell extension of infection. Neural cell infection and endothelial damage lead to an inflammatory response and disruption of the blood-brain barrier with chemokine production and recruitment and activation of neutrophils.
Listeria monocytogenes is a zoonotic agent. Listeriosis in humans is a rare disease with high mortality (20-30%). Generally, it is a self-limiting foodborne illness. Certain risk groups (pregnant women, neonates, adults 65 years of age and over and individuals with compromised immune systems) may develop invasive disease one to four weeks following an episode of food borne illness. Invasive disease may include pregnancy complications (miscarriage, stillbirth, premature delivery due to in utero infection), life-threatening infection of the newborn, septicemia, meningitis and meningoencephalitis. Occasionally, it is an occupational disease of veterinarians and farmers, usually contracted from direct contact with infected livestock or their products of conception. To prevent contamination by Listeria monocytogenes in food processing establishments, cleaning and disinfection of facilities must be emphasized, with attention paid to proper maintenance and temperature control of food refrigeration equipment.
Contributing Institution:
United States Army Medical Research Institute of Infectious Diseases
https://www.usamriid.army.mil
JPC Diagnoses:
1. Cervical spinal cord: Meningomyelitis, suppurative, subacute, multifocal, moderate, with microabscesses.
2. Brainstem and cerebellar white matter: Leukoencephalitis, suppurative, subacute, multifocal, mild to moderate, with microabscesses and lymphohistiocytic meningitis.
JPC Comment:
This week’s conference was moderated by MAJ Sarah Sulkosky, a former WSC coordinator! Listeria monocytogenes has already been seen this year in a case of sepsis in a non-
human primate (Conference 10, Case 3), but the CNS presentation of listeriosis, particularly in a small ruminant, is worth its own conversation. The contributor provides a wonderful write-up on this entity, which contains most of what was discussed in conference. There was a quick discussion on the important features needed histologically to properly identify vasculitis, which include
cellular debris in the vessel wall, and extrusion of protein (which often contains polymerized fibrin ) into the wall.
Listeria monocytogenes was first described in 1926 by Murray as Bacterium monocytogenes after isolating it from the livers of diseased rabbits and guinea pigs.1 A year later in 1927, Pirie isolated a similar organism from gerbils and proposed the genus name Listerella in 1930 to honor British surgeon and antiseptic technique frontman, Dr. Joseph Lister.1 Dr. Lister discovered that sterilizing surgical instruments prior to use resulted in fewer post-operative infections. He is also the inspiration behind the name for one of our most popular antiseptic brands, “Listerine.” "Listerella", however, was a name previously used for a slime mold, so Pirie changed the name to Listeria in 1940.1
In cases of listeric encephalitis, Listeria monocytogenes is most classically associated with a rhombencephalitis, which is inflammation of the brainstem and cerebellum. These areas are most often affected due to the retrograde axonal transport Listeria makes along the trigeminal nerve. The sensory root for the trgimenal nerve emerges from the ventrolateral aspect of the pons, specifically the middle cerebellar peduncle, which connects the pons to the cerebellum.3
References:
- Etymologia: Listeria. Emerg Infect Dis. 2016;22(4):633.
- Maxie MG, Youssef S. Nervous System. In: Maxie MG, ed. Jubb, Kennedy and Palmer's Pathology of Domestic Animals. Vol I. 5th ed. Elsevier; 2007:405-408.
- Ogino MH, Tadi P. Neuroanatomy, Trigeminal Reflexes. In: StatPearls [Internet]. Treasure Island (FL): StatPearls Publishing; 2025.
- Zachary J. Mechanisms of Microbial Infections. In: Zachary J, McGavin MD, ed. Pathologic Basis of Veterinary Disease. 5th ed. Elsevier, 2012:192-195.
- Zachary J. Nervous System. In: Zachary J, McGavin MD, ed. Pathologic Basis of Veterinary Disease. 5th ed. Elsevier, 2012:845-846.
- https://www.fda.gov/.../get-facts-about-listeria
- https://www.cdc.gov/listeria/index.html.
- https://www.canr.msu.edu/news/listeriosis-in-sheep-and-goats.